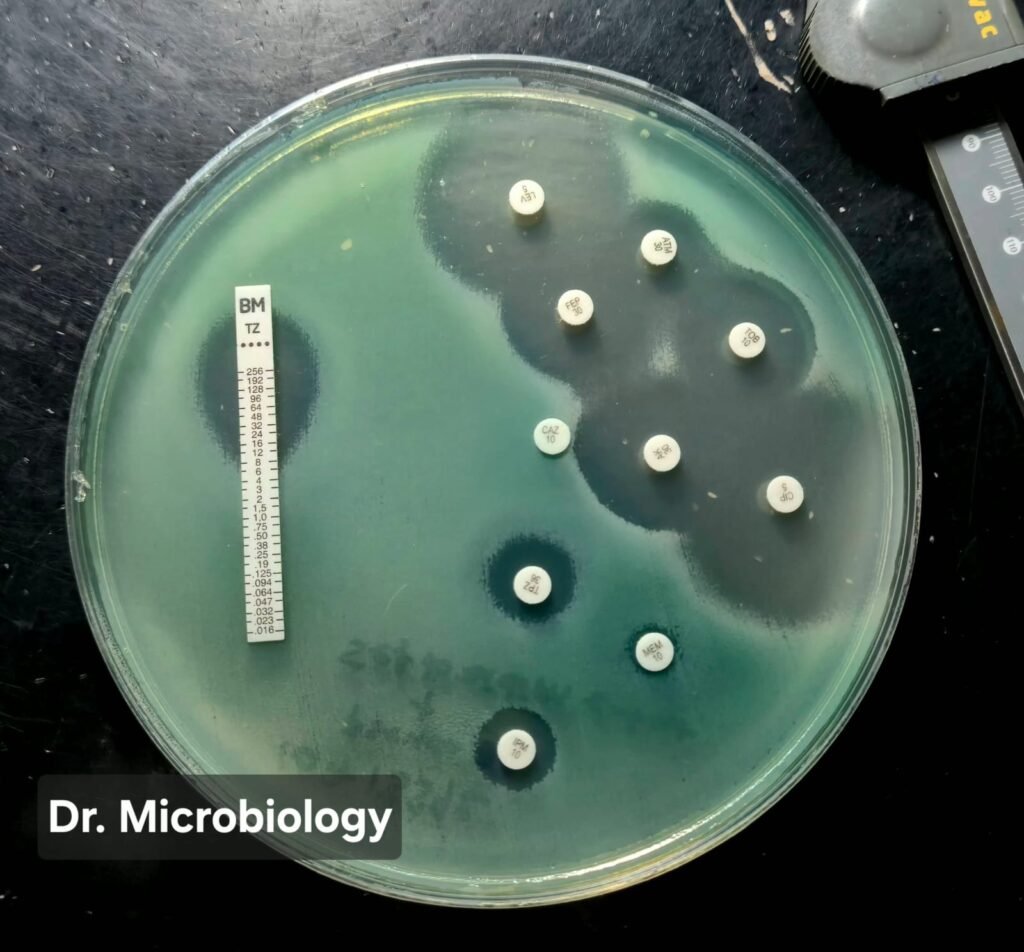
Pseudomonas aeruginosa antibiotic resistance disk diffusion test on Mueller-Hinton agar
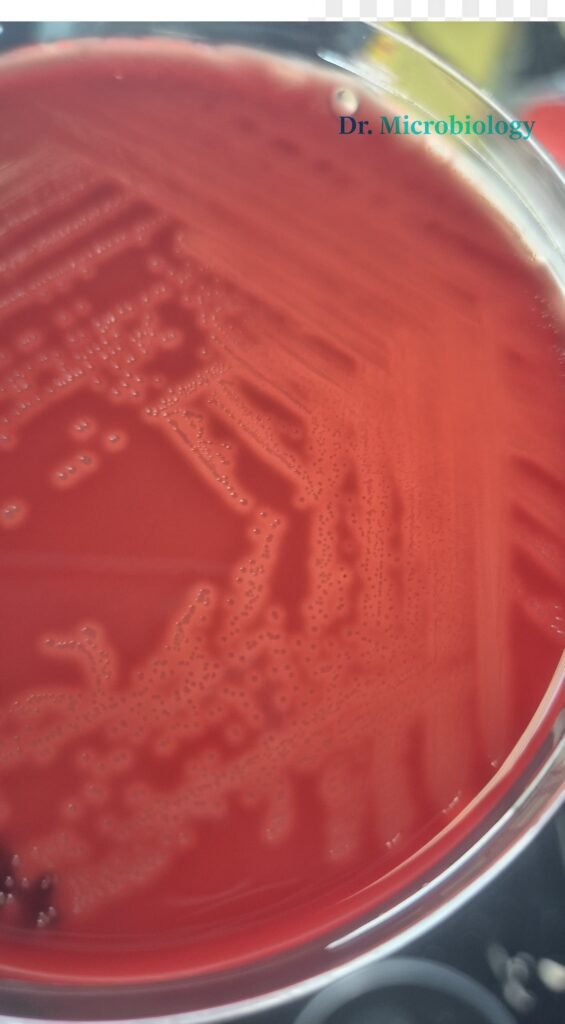
Streptococcus Pygones Blood Agar

Pseudomonas aeruginosa Antibiotic Resistance: Mechanisms, Carbapenem Resistance and Clinical Impact
Author: Semih Başaran, MD – Clinical Microbiology Resident Introduction to Pseudomonas aeruginosa Antibiotic Resistance Pseudomonas aeruginosa antibiotic resistance represents one of […]